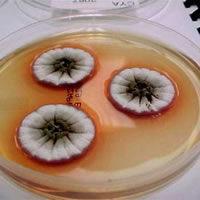

Pocket K No. 20: Microbial Fermentation
| |
For many years, man has worked to improve agricultural productivity by taking advantage of the work of millions of soil microbes. These microbes can be cultivated on a large scale and made to produce important biofertilizers, to assist plant growth; and biopesticides, to control weeds, pests, and diseases. This process is known as microbial fermentation.
Microbes function as both providers and defenders. They can contribute to plant nutrition by converting important macromolecules into forms usable by plants, as biofertilizers; or they can defend plants from other invasive, parasitic plants and pests, as bioherbicides and bioinsecticides.
Biofertilizers
Phosphate and nitrogen are important for plant growth. However, plants have a limited ability to extract them from the environment, and thus need microbes to help them absorb these nutrients at optimal concentration.
Source: http://www.dehs.umn.edu/iaq/ fungus/penicillium/bilaii.html |
| Colonies of Penicillium bilaii growing on a culture plate |
These same microbes are also involved in “nutrient recycling,” i.e. they help a plant take up energy sources, while plants donate waste byproducts to microbes for food. With this symbiotic relationship, plants develop stronger and bigger root systems. The larger the plants’ roots, the more living space and food there is for the microbes to use. In a way, microorganisms serve as biofertilizers.
An example is the fungus Penicillium bilaii, which allows plants to absorb phosphates from the soil. It does this by producing an organic acid which dissolves soil phosphates into a form which plants may use. A biofertilizer made from this organism is applied either by coating seeds with the fungus (called inoculation), or applying the fertilizer directly into the ground.
Another example is the bacterium Rhizobium. This bacterium lives on the plant’s roots in cell collections called nodules. The nodules are biological factories that can take nitrogen out of the air and convert it into an organic form that the plant can use. Because the bacteria live within the roots, they transfer the nutrient directly into the plant. Rhizobium works with legumes, such as beans, groundnut, and soybean.
Biofertilizers have been found to:
- Increase crop yield by 20-30%.
- Replace chemical nitrogen and phosphorus by 25%.
- Stimulate plant growth.
- Activate the soil biologically.
- Restore natural soil fertility.
- Provide protection against drought and some soil borne diseases.
Bioinsecticides
Insect pests of important crops can be difficult to control. Thanks to fermentation methods, however, bioinsecticides have been developed, based on the insecticidal proteins of bacteria, fungi, and viruses.
Bacteria-based bioinsecticides
 Source: http://www.microbelibrary.org |
| Bacillus sp. |
One of the most widely used bioinsecticides is a naturally occurring soil bacterium called Bacillus thuringiensis or Bt. Bt produces a protein which is poisonous to insects. Within 15 minutes of being eaten, the Bt toxin begins to create ulcers in the insect’s stomach lining. The insect stops eating and eventually dies. Researchers have identified between 500 and 600 strains, or types of Bacillus thuringiensis. Bt is very selective — it affects only a specific species of insect pest and does not harm humans, birds, fish, or beneficial insects.
Fungi-based bioinsecticides
Some fungi can cause disease in insects, and as many as 200 different insects are known to be susceptible to such diseases. These fungi are thus used in fungi-based bioinsecticides.
 Source: Keith Weller/USDA |
| Culture of Beauveria bassiana fungus |
Inexpensive fermentation technology is used to mass produce fungi. Spores are harvested and packaged so they can be applied to insect-ridden fields. When the spores are applied, they use enzymes to break through the outer surface of the insects’ bodies. Once inside, they begin to grow and eventually cause death.
One bioinsecticide, Bb, is based on the action of Beauveria bassiana, a fungus which is found worldwide in soils and plants. In China, over two million hectares are sprayed with Bb annually to control forestry pests.
Bioinsecticides based on Bb have many advantages. The fungus does not grow in warm-blooded organisms (such as humans), nor does it survive long in water reservoirs or rivers. However, its spores can withstand long periods of dryness and other harsh environmental conditions. Studies to date have shown that the fungus also does not harm plants and becomes inactivated by the sun’s ultraviolet rays in one to eight weeks.
Virus-Based Bioinsecticides
Insect pests are also susceptible to viral diseases, and virus-based insecticides exploit this property in order to control the spread of pests.
An example currently being tested is the Baculovirus group. Baculoviruses affect insect pests like corn borers, potato beetles, flea beetles, and aphids. One particular strain is being used as a control agent for Bertha army worms. These worms attack canola, flax, and vegetable crops, and have been known to clean out as many as one million hectares of prairie crops at high infestation levels. Farmers used chemical insecticides to control the worms in the past. Bioinsecticides do not persist long in the environment, unlike synthetic pesticides. They also have shorter shelf lives and are effective in small quantities, safer to humans and animals compared to synthetic insecticides, and very specific, often affecting only a single species of insect. However, bioinsecticides also have some disadvantages. They work slowly and the timing of their application is relatively critical. Moreover, because most of these bioinsecticide agents are living organisms, their success is affected by several factors like temperature, pH, moisture, UV, soil conditions, and other microbial competitors present in the environment.
Bioherbicides
Weeds are a constant problem for farmers. They compete with crops for water, nutrients, sunlight, and space; harbor insect and disease pests; clog irrigation and drainage systems; undermine crop quality; and deposit weed seeds into crop harvests. If left uncontrolled, weeds can reduce crop yields significantly.
 Source: Scott Bauer/USDA |
| Wasps injecting their eggs into oriental fruit fly eggs |
Farmers fight weeds with tillage, hand weeding, synthetic herbicides, or a combination of all techniques. Unfortunately, tillage leaves valuable topsoil exposed to wind and water erosion, a serious long-term consequence for the environment. For this reason, more and more farmers prefer reduced or no-till methods of farming.
The use of bioherbicides is another way of controlling weeds without the environmental hazards posed by synthetic herbicides. Bioherbicides are made up of microorganisms and certain insects (e.g. parasitic wasps, painted lady butterfly) that can target very specific weeds. The microbes possess invasive genes that can attack the defense genes of the weed, thereby killing it.
Due to better understanding of the genetics of both microorganisms and plants, scientists have been able to isolate pathogens whose genes match particular weeds, and which can cause fatal diseases in those weeds, and in those weeds alone. Some bioherbicides contain such microorganisms, and they are sent out into the field when weeds are most susceptible to illness. The specificity of the microbes for a specific weed makes such bioherbicides very useful, since they can kill only certain weeds without damaging important crops.
Bioherbicides can also survive in the environment long enough for the next growing season, when there will be more weeds to infect. They are cheaper compared to synthetic pesticides, and could essentially reduce farming expenses if managed properly.
Bioherbicides and StrigaSub-saharan Africa is home to fields of sorghum and corn, as well as a weed that parasitizes either crop. Striga can wipe out hectares and hectares of important cereals, lowering crop yields and increasing the cost of planting and production.
Using bioherbicides coupled with work on genetic modification of certain cereals, scientists have been able to lower Striga parasitism and increase corn and sorghum harvests. Sorghum seeds, for instance, can be inoculated with Fusarium, a fungus, through a coating of Arabic gum. The preparation of the coating material and inoculum itself takes up to 14 days and is conducted by village women. The most recent Striga shield is a new hybrid maize called Ua Kayongo, whose seeds are coated with the Strigaway herbicide. Ua Kayongo is Imazapyr Resistant maize (IR-maize), whose resistance is based on a naturally occurring herbicide resistance in maize, and which was later incorporated into Kenyan maize varieties by African plant breeders at the International Maize and Wheat Improvement Center (CIMMYT) and the Kenya Agricultural Research Institute (KARI). |
Conclusion
As biofertilizers, microorganisms can work symbiotically with plants while receiving their own nutrition. As bioherbicides, they can work alone, or in concert with other species, to remove weeds. And, as bioinsecticides, they protect plants from destructive pests. Although microorganisms are often labeled as dangerous or deadly, they can actually be instrumental in saving crops, increasing yields, and protecting soils for the next planting season.
| |
References:
Inoculant Encyclopedia (http://www.inoculants.com/encyclopedia/encyclopedia_5.html)
- Integrated Pest Management Resource Centre. Biopesticides. (http://www.ipmrc.com/expert/biopesticides/index.shtml)
- Integrated Plant Protection Center. Database of Microbial Biopesticides. (http://www.ippc.orst.edu/biocontrol/biopesticides/)
- International Biopesticide Consortium for Development. Biopesticides. (http://www.biopesticide.org/biopesticides.htm)
- UPLB Compendium of Mature and Developed Technologies. (http://www.uplb.edu.ph)
- Biofertilizers (http://edugreen.teri.res.in/explore/bio/ferti.htm)
- FAQ’s on Biofertilizers (http://www.vusat.org/learning/agri/FAQs/biofertilizer.htm)
- Soil Bacteria (http://soils.usda.gov/sqi/soil_quality/soil_biology/bacteria.html)
- Indoor Fungi Resources (http://www.dehs.umn.edu/iaq/fungus/penicillium/bilaii.html)
*November 2006
Next Pocket K: Gene Switching and GURTs: What, How and Why?
-
Foldable Version (PDF)
- English
- Bahasa Indonesia
-
Document Version (PDF)
- English

